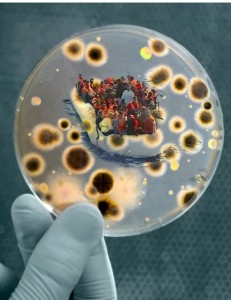

(ANSAmed) – ATENE – E’ allarme Aids ad Atene dopo che, negli ultimi giorni, 10 prostitute immigrate illegali sono risultate positive al test del virus Hiv e un centinaio sono state arrestate e tuttora sono sottoposte ad analisi mediche. Il sindaco di Atene, Yiorgos Kaminis, ha chiesto una riforma delle leggi che regolano l’esercizio della prostituzione (che in Grecia e’ legale), dopo un giro di vite sulle case chiuse clandestine nel centro della capitale greca che ha portato sinora in prigione 96 prostitute soprattutto provenienti dai Paesi dell’Est Europa e dall’Africa.
La scoperta che una decina di queste donne sono affette dal virus HIV, e la notizia del conseguente aumento dei casi di Aids registrati negli ultimi mesi, ha scatenato una vera e propria psicosi ad Atene. Dopo che i media hanno diffuso la notizia dell’arresto delle prostitute infette, oltre mille persone – che avevano usufruito delle prestazioni sessuali a pagamento senza protezione – hanno chiamato il Centro per il Controllo delle Malattie e la Prevenzione (Keelpno) per chiedere come regolarsi.
La maggioranza delle telefonate proveniva da uomini sposati e con figli, di età compresa tra i 35 e i 45 anni. Tra questi anche diversi ragazzi di meno di 16 anni[nbnote ]http://www.ansamed.info/ansamed/it/notizie/rubriche/cronaca/2012/05/02/Grecia-Atene-allarme-Aids-prostitute_6802656.html[/nbnote].
Un velo pietoso ovviamente su questi uomini che, non solo, tradiscono la fiducia delle loro donne, ne mettono anche in pericolo la salute e la stessa vita.
Ma visto che viviamo in un mondo dove esistono i dementi, sarebbe bene che le autorità lavorassero, per proteggere la società nel suo complesso dai comportamenti sbagliati di alcuni suoi membri. E questo, lo si potrebbe fare evitando l’ingresso di immigrati da zone dove l’Aids è una malattia endemica: Africa Nera e alcuni paesi dell’Est.
Invece questo non viene fatto. E non viene neanche fatto alcun controllo preventivo.
Se per una volta, in un paese europeo si è fatto il controllo obbligatorio, e il 12% delle prostitute immigrate è risultato positivo, è difficile pensare sia un “caso”. E’ piuttosto invece, probabile, questo sia un numero “per difetto”, vista l’incidenza della malattia in alcuni paesi africani.
Perché l’Aids in Italia e in Europa, si diffonde ormai solo e soltanto, attraverso gli immigrati e i loro frequentatori xenofili. Puttanieri compresi.
[nbnote print=”true”]